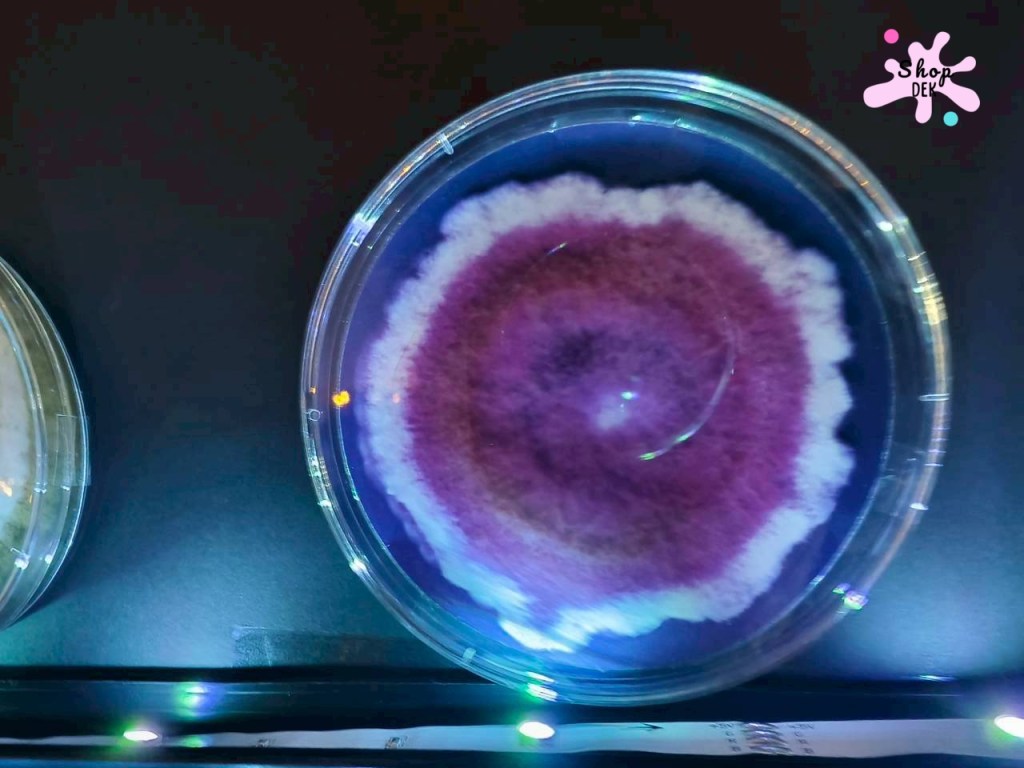
จุดประกายนักวิทยาศาสตร์รุ่นเยาว์ ที่พิพิธภัณฑ์ตอนกลางคืน คณะวิทยาศาสตร์ จุฬาฯ
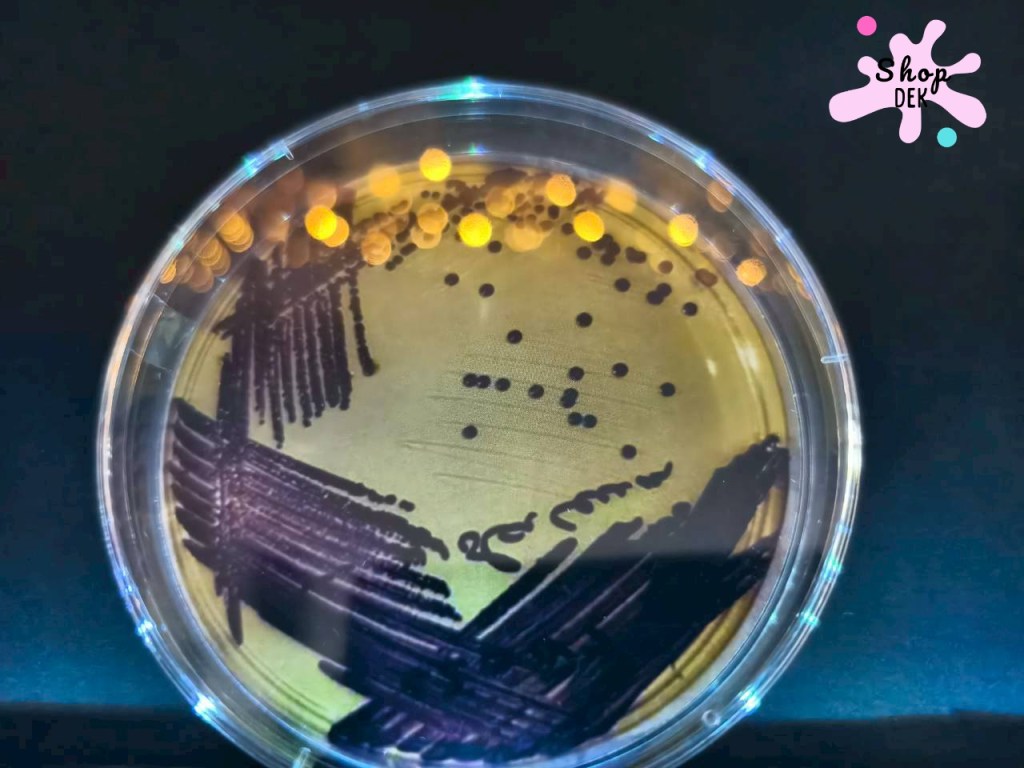
จุดประกายนักวิทยาศาสตร์รุ่นเยาว์ ที่พิพิธภัณฑ์ตอนกลางคืน คณะวิทยาศาสตร์ จุฬาฯ
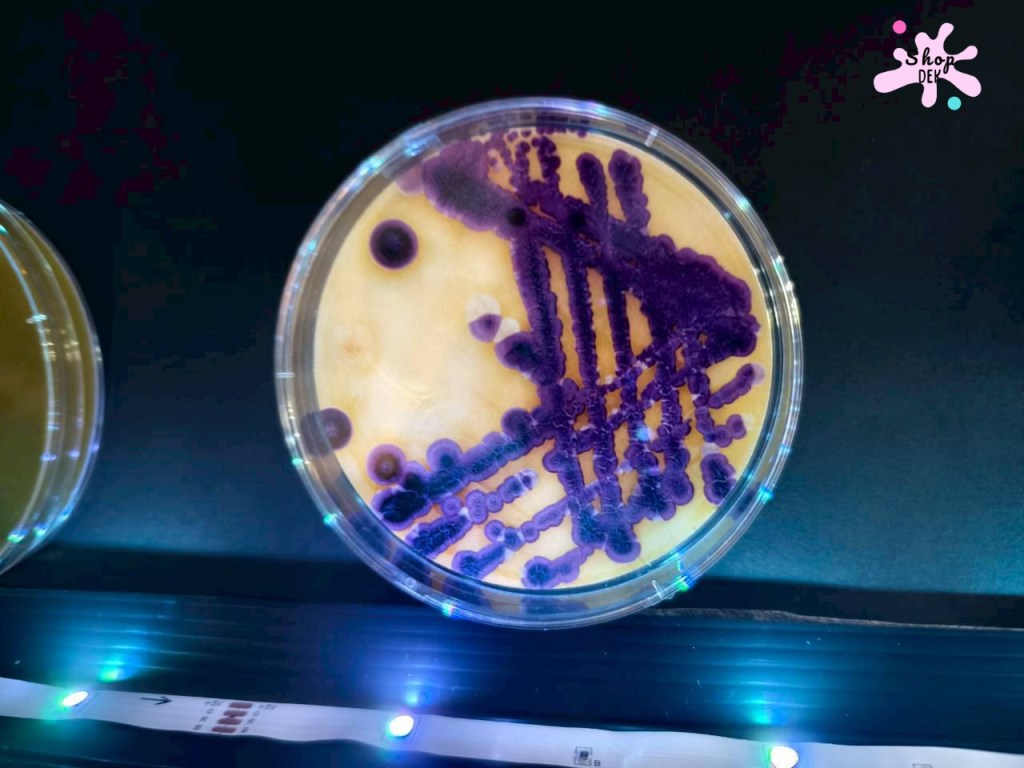
จุดประกายนักวิทยาศาสตร์รุ่นเยาว์ ที่พิพิธภัณฑ์ตอนกลางคืน คณะวิทยาศาสตร์ จุฬาฯ
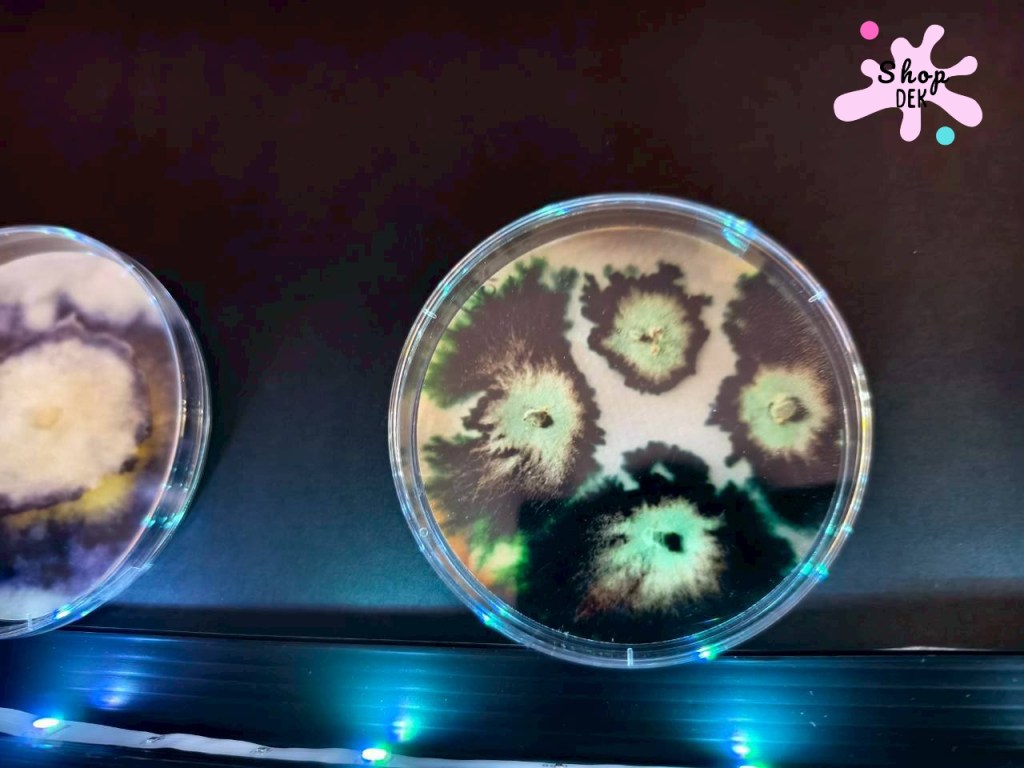
จุดประกายนักวิทยาศาสตร์รุ่นเยาว์ ที่พิพิธภัณฑ์ตอนกลางคืน คณะวิทยาศาสตร์ จุฬาฯ

กลับมาอีกครั้งกับงานพิพิธภัณฑ์ตอนกลางคืน Night Museum@Chula ซึ่งจะจัดทุกปลายปีช่วงเดือนธันวาคม ในระยะเวลาเพียง 3 วันเท่านั้น ในปีนี้จัดวันที่ 12 – 14 ธันวาคม 2568 ธีมงาน “มองเมืองผ่านเลนส์วิทยาศาสตร์” เข้าชมฟรีตลอดทั้งงาน (ยกเว้นบูธของที่ระลึก)

ภายในงานมีการจัดบูธให้ร่วมทำกิจกรรมต่างๆ จากพี่ๆ นิสิตคณะวิทยาศาสตร์ ภาควิชาต่างๆ อาทิ
- ภาควิชาชีววิทยา จัดแสดงเปิดพิพิธภัณฑ์ธรรมชาติวิทยา ให้น้องๆ หนูๆ และผู้สนใจทั่วไปได้เข้าชมโครงกระดูกสัตว์ต่างๆ เพื่อการศึกษาด้านอนุกรมวิทยา
- ภาควิชาเคมี เปิดห้องทดลอง จัดฐานต่างๆ ให้หนูน้อยได้วาดภาพ ระบายสี เรียนรู้การทดลองง่ายๆ
- ภาควิชาจุลชีววิทยา จัดแสดงจานเลี้ยงเชื้อจุลินทรีย์ชนิดต่างๆ ที่มีบทบาทสำคัญการค้นคว้า ทดลอง เพื่อผลิตอาหาร ยา ฯลฯ
- ภาควิชาฟิสิกส์ ตั้งกล้องดูดาว ที่ลานพระรูปสองรัชกาล เพื่อให้มองเห็นดวงดาวตามฤดูกาล
คำถามก่อนอื่นเลย ถ้ามาแบบครอบครัว ควรจอดรถไว้ที่ไหน? .. มีคำแนะนำจากรุ่นพี่ศิษย์เก่า ให้จอดที่อาคารจอดรถคณะรัฐศาสตร์ ซึ่งเดินมาฝั่งคณะวิทยาศาสตร์ได้จากถนนเดียวกัน ระยะ 200 – 300 เมตรเท่านั้นเองค่ะ

มีจุดลงทะเบียนใหญ่ๆ ทั้งหมด 3 จุด ได้แก่ ตรงหน้าลานไดโนเสาร์ภาคธรณีวิทยา, ตรงกลางงานอยู่ใกล้ๆ ตึกแถบ และทางประตูพระรูปสองรัชกาล ใกล้ๆ หน้าตึกขาว


เพื่อนๆ ลงทะเบียนแล้วจะได้ใบนี้มาเพื่อ Stamp และชิงโชคจับรางวัลผู้โชคดีระหว่างวันที่ลงทะเบียนด้วยค่ะ บ้านเราลงทะเบียนที่หนาภาควิชาธรณีวิทยา ตรงที่มีไดโนเสาร์เยอะๆ วินเนอร์วิ่งพุ่งไปหาพี่ๆ เล่นเกมจับฉลากจับของรางวัล ได้เป็นไม้บรรทัดไดโนเสาร์เอาไว้ไปโรงเรียน ส่วนแป้งหอมจับได้ตุ๊กตา และน้ำยาล้างจาน ของใช้ในบ้าน ไม่ซ้ำกัน



เช็คอินที่แรก เข้าไปดูพรรณไม้หายาก ตื่นตาตื่นใจกับไม้กินแมลง กับดอกไม้สวยๆ ต่างๆ ซึ่งการจัดสวนให้เหล่าพันธุ์ไม้ออกมาปังขนาดนี้ จะต้องใช้ความรู้ประมาณนึง (รายได้ดีด้วยแหละ) เสียดายตอนนั้นแม่ไม่ได้เรียนสาขานี้ ไม่อย่างนั้นตอนนี้รวยเละ







มีกิจกรรมวาดภาพระบายสี และมีการอธิบายเกี่ยวกับสีที่เกิดจากพืชธรรมชาติอีกด้วย คนที่อินคือแป้งหอม ส่วนวินเนอร์นี่วิ่งตลอด ต้องพาออก
ในที่สุดเราก็มาเจอสิ่งที่วินเนอร์อิน นั่นก็คือห้องจัดแสดงของสาขาวิชาเคมี เป็นห้องที่เดินง่าย แอร์เย็น และมีกิจกรรมฉ่ำมาก มีการทดลองวิทยาศาสตร์ วาดภาพบนผ้าเช็ดหน้าและย้อมคราม และมีการสอนเรื่องสารเคมีในชีวิตประจำวันที่เข้าใจง่าย

สุดท้ายนี้อยากจะบอกว่า ใครที่มาเป็นครั้งแรก มาวันเดียวอาจจะไม่พอ เก็บไม่หมดจริงๆ กิจกรรมเขาแน่น พาลูกมาเล่น ได้สัมผัสกับนักวิทยาศาสตร์ตัวจริง มีอะไรก็ถามพี่ๆ และอาจารย์ประจำภาคได้ ต่อยอดความฝันให้กับเด็กๆ ถึงอนาคตจะไม่ได้เรียนคณะวิทยาศาสตร์ แต่ก็มีแรงบันดาลใจให้กับน้องๆ ได้ต่อยอดความเป็นนักเรียนรู้ในอนาคต
.
ไปค่ะ ! ใครที่มีลูกวัย 3 ขวบครึ่งขึ้นไป น้องน่าจะอิน งานมีถึงวันอาทิตย์ที่ 14 ธันวาคม 2568 ปิด 22.00 น. มีอาหารการกินอิ่มแน่นอน สำหรับใครที่วางแผนอยู่ ขออนุญาตแปะกำหนดการต่างๆ ได้ด้านล่างนี้นะคะ
.
ประชาสัมพันธ์กำหนดการงาน Night Museum@chula มองเมืองผ่านเลนส์วิทยาศาสตร์ วันที่ 12-14 ธันวาคม 2568 ณ คณะวิทยาศาสตร์ จุฬาฯ
.
วันศุกร์ที่ 12 ธันวาคม 2568
16.00 น. ลงทะเบียนพร้อมกัน ณ พิพิธภัณฑ์จัดงานพร้อมเยี่ยมชมนิทรรศการ
17.00 น. เริ่มแสดงดนตรี ณ ลานอะตอม
18.00 น. พิธีเปิดกิจกรรม ณ ลานอะตอม
18.30 น. การแสดงดนตรีวงเครื่องสายสากล โดย คณะศิลปกรรมศาสตร์
19.20 น. จับรางวัลสำหรับผู้ลงทะเบียน (รอบที่ 1)
19.30 น. เสวนา “ปูราชินี” สัตว์ในพระนามพระมารดาแห่งความหลากหลายทางชีวภาพ โดยภาควิชาชีววิทยา
20.30 น. จับรางวัลสำหรับผู้ลงทะเบียน (รอบที่ 2)
20.40 น. การแสดงดนตรีจากนิสิตชมรมดนตรี สโมสรนิสิตคณะวิทยาศาสตร์
22.00 น. ปิดการแสดง/พิพิธภัณฑ์
.
วันเสาร์ที่ 13 ธันวาคม 2568
16.00 น. ลงทะเบียนและเปิดกิจกรรมพร้อมกัน ณ พิพิธภัณฑ์จัดงานพร้อมเยี่ยมชมนิทรรศการ
18.00 น. การแสดงดนตรีวงเครื่องสายสากล โดย คณะศิลปกรรมศาสตร์
19.00 น. จับรางวัลสำหรับผู้ลงทะเบียน (รอบที่ 1)
19.30 น. เสวนา ยาดมไทย: เปลี่ยนผ่านภูมิปัญญา สู่มาตรฐานสากล โดยภาควิชาจุลชีววิทยาและภาควิชาพฤกษศาสตร์
20.30 น. จับรางวัลสำหรับผู้ลงทะเบียน (รอบที่ 2)
20.40 น. การแสดงดนตรีจากนิสิตชมรมดนตรี สโมสรนิสิตคณะวิทยาศาสตร์
22.00 น. ปิดการแสดง/พิพิธภัณฑ์
.
วันอาทิตย์ที่ 14 ธันวาคม 2568
16.00 น. ลงทะเบียนและเปิดกิจกรรมพร้อมกัน ณ พิพิธภัณฑ์จัดงานพร้อมเยี่ยมชมนิทรรศการ
18.00 น พระพันปีหลวง ผู้ชุบชีวิต “ผ้าไทย” โดยภาควิชาวัสดุศาสตร์
19.00 น. จับรางวัลสำหรับผู้ลงทะเบียน (รอบที่ 1)
19.30 น. เสวนา “Mona Lisa: Night Light Scan” โดยศูนย์วิทยาศาสตร์เพื่อการอนุรักษ์งานศิลปะ (SCICCA)
20.30 น. จับรางวัลสำหรับผู้ลงทะเบียน (รอบที่ 2)
20.40 น. การแสดงดนตรีจากนิสิตชมรมดนตรี สโมสรนิสิตคณะวิทยาศาสตร์
22.00 น. ปิดการแสดง/พิพิธภัณฑ์
อ่านบทความที่เกี่ยวข้อง
- Dream World เปิด ปิด กี่โมง? พร้อมอัปเดตราคาบัตรรวมเครื่องเล่นล่าสุด!
- 10 สวนสนุกสำหรับเด็ก และครอบครัว ไม่ปิดเทอมก็ไปได้
- พาเที่ยว ! Happy Sunshine Park โลกหิมะ เมืองหิมะรังสิต ปทุมธานี
- LandLab ไทรน้อย นนทบุรี พาลูกเล่นบรรยากาศธรรมชาติ
- วันเด็ก 2568 อาชีพในฝันอยากเป็นนักบินไปกองทัพอากาศ ดอนเมืองกันเถอะ





ใส่ความเห็น